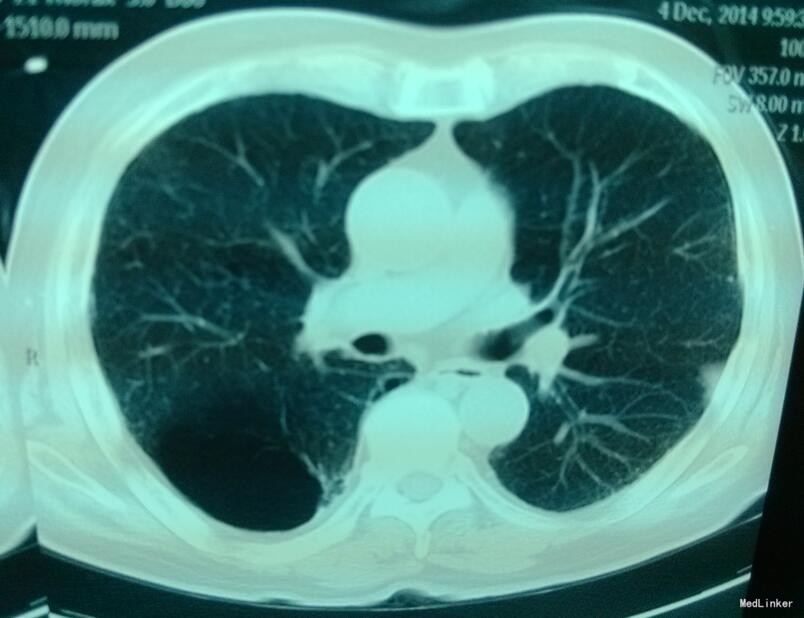

打开应用右肺上叶肺大泡一例
患者为71岁老年男性,吸烟40+年,反复咳嗽咳痰,此次因右侧胸痛就诊。
胸部CT提示双肺散在感染灶,右上肺肺大泡,伴胸膜增厚。
诊断为:1、右上肺肺大泡,2、COPD。患者经内科保守治疗后稍好转,遂继续观察。
肺大泡是一种不可逆转的肺部病损,故无有效的药物治疗。手术是一个的治疗措施,但并非所有的肺大泡病人均需手术治疗。偶然发现的无症状的肺大泡一般勿需治疗,伴有慢性支气管炎或肺气肿的患者,主要治疗原发病变。继发感染时,应用抗生素。如果大泡大于一侧胸腔的1/3~1/2,即被称为巨大肺大泡,因其可压迫周围肺组织,改变通气-血流比,故手术可取的良好效果。如果实质内肺大泡分布广泛,外科治疗仅为姑息性。
- 连琼霞回复赵军:确实是很常见到,是否结核病人合并肺大疱在治疗上更为棘手呢
肺大泡如果能有明显症状,不符合手术指征,保守治疗的同时注意告诫病人改变不良生活习惯,同时进行适当训练,提高心肺功能。
肺大泡在影像上看比较明显,肺窗上没有血管纹理。平时需要注意些什么呢,如果不手术切除的话会不会平时间发生破裂引起气胸?
肺大泡是阻塞性肺气肿的一种,吸烟40年,一点都不奇怪。70多岁了,其实也无所谓,只不过他接下来这几年会很难过,超不过10年,就会肺心病,最后肺性脑病死掉。作为医...查看全部
我想知道这种肺大泡你们还给患者做肺功能吗
很典型的copd,对于这种常年吸烟的患者只能是劝其戒烟或者少吸烟,就怕诱因一存在就容易出现气胸。
这种肺大泡一旦出现呼吸困难加重一方面想的气胸,另一方面有可能张力增加的肺大泡,需要鉴别,后者避免穿刺引流,可造成病情急剧恶化甚至死亡,在尘肺晚期常常见到。
肺大疱临床常常见到,对于一些结核病人一有时真的是束手无策呀
这例患者手术比保守治疗效果好些吧
这个病人没有呼吸困难吗?COPD诊断的依据仅靠影像学和吸烟史吗?求指教。另外还是认为该病例的肺大泡手术效果会好些。
应该结合临床表现诊断copd,吸烟是copd常见的病因,患者出院随访应考虑copd分级给予针对性治疗
学习了。